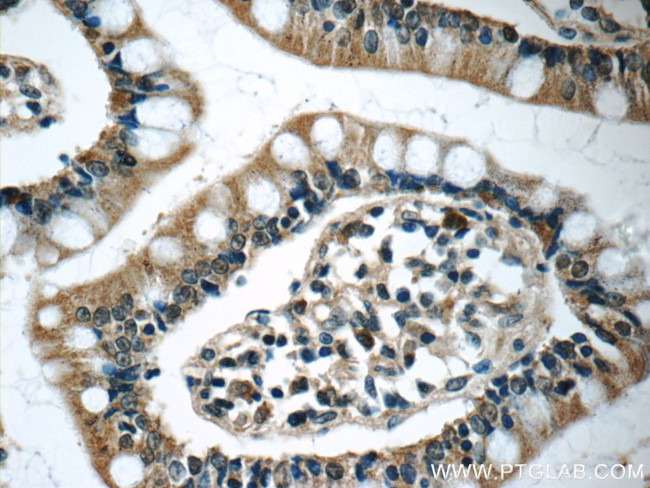
humanin Antibody in Immunohistochemistry (Paraffin) (IHC (P))

Search
Proteintech
humanin Polyclonal Antibody
{{$productOrderCtrl.translations['antibody.pdp.commerceCard.promotion.promotions']}}
{{$productOrderCtrl.translations['antibody.pdp.commerceCard.promotion.viewpromo']}}
{{$productOrderCtrl.translations['antibody.pdp.commerceCard.promotion.promocode']}}: {{promo.promoCode}} {{promo.promoTitle}} {{promo.promoDescription}}. {{$productOrderCtrl.translations['antibody.pdp.commerceCard.promotion.learnmore']}}
产品信息
25885-1-AP
种属反应
宿主/亚型
分类
类型
抗原
偶联物
形式
浓度
规格
纯化类型
保存液
内含物
保存条件
运输条件
靶标信息
Humanin is a novel 24 A. A polypeptide identified in Alzheimer's disease-affected brain. It is 99% homologous to mitochondrial 16s ribosomal RNA and functions as a novel neuroprotective and cytoprotective factor. It specifically inhibits neuronal cell death induced by beta-amyloids and Alzheimer's disease causing FAD genes by competitively inhibiting access of FPRL1 receptor to beta-amyloids. It acts as an anti-apoptotic factor by binding to Bcl-2/Bax family of pro-apoptotic factors including Bax, Bak, Bid and BimEL and inhibits their pro-apoptotic activity. It activates JAK/STAT signaling pathway and is regulated by TRIM11. It interacts with IGFBP-3 and specifically blocks IGFBP-3 induced cell death in glioblastoma cells. Humanin is also expressed in colon and testis.
仅用于科研。不用于诊断过程。未经明确授权不得转售。
篇参考文献 (0)
生物信息学
蛋白别名: BCL2L4